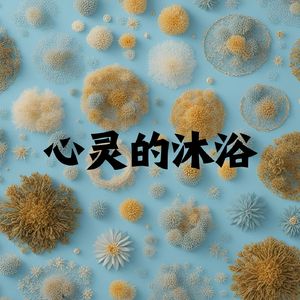
闲云野鹤 (日本笛)

纯洁白 (疏肝解郁)
养生音乐馆

诗酒趁年华 养生冥想曲
养生音乐馆, 纯音乐

音律的疗愈魔法 (疏肝解郁)
养生音乐馆

五音养生·羽音(缓解疲劳 补肾益气)
中医养生音乐馆

五音养生·宫音(调和脾胃 消食化湿)
中医养生音乐馆

五音养生·徵音(醒脑开窍 疏通血脉)
中医养生音乐馆

梦玲珑 (抗抑郁)
养生音乐馆

流古韵 (疏肝解郁)
养生音乐馆

心神往 (疏肝解郁)
养生音乐馆

闲云野鹤 (日本笛)
养生音乐馆

轻柔之乐 (温馨音乐)
养生音乐馆

宝宝睡觉觉 (八音盒 哄睡)
养生音乐馆

韵味 (八音盒)
养生音乐馆

安抚婴儿 (八音盒 哄睡)
养生音乐馆

墨香书韵 (提高专注力)
养生音乐馆

宁静的山谷 (提高专注力)
养生音乐馆

水墨兰亭 (古筝)
养生音乐馆

淮古遗殇 (古筝)
养生音乐馆

睡前音乐会 (八音盒 哄睡)
养生音乐馆

山水 (古筝)
养生音乐馆

花间梦事 (古筝)
养生音乐馆

倚楼 催眠学习曲
养生音乐馆, 纯音乐

半壶纱 (古筝)
养生音乐馆

梦回还 (古筝)
养生音乐馆

清音流水 (竖琴)
养生音乐馆

让胎儿安静入睡 (深度睡眠)
养生音乐馆

图书馆轻音乐 (高效学习旋律)
养生音乐馆

夏雨风荷 (古筝)
养生音乐馆

云村的风 (竖琴)
养生音乐馆

婴儿的睡前小曲 (八音盒 哄睡)
养生音乐馆

孕期催眠曲 (温馨音乐)
养生音乐馆

梦玲珑 (冥想)
养生音乐馆

古筝禅境 (竖琴)
养生音乐馆

爱心 (催眠曲)
养生音乐馆

梦悠然 (古筝舒缓)
养生音乐馆

氛围古乐 (古筝)
养生音乐馆

平心静气 (古琴)
养生音乐馆

舒心的一天 (疏肝解压)
养生音乐馆
一念清静 (古琴)
养生音乐馆

修养生息 (静心曲)
养生音乐馆

花儿与小婴儿 (八音盒 哄睡)
养生音乐馆

智慧之光 (笛子修心)
养生音乐馆

梦幻小曲 (夜间环境氛围)
养生音乐馆

琴悠扬
养生音乐馆

云水逸 (古筝)
养生音乐馆

学习之歌 (我爱学习)
养生音乐馆

悬崖勒马 (古筝疗愈)
养生音乐馆

轻歌 (竖琴)
养生音乐馆

温柔之曲 (温馨音乐)
养生音乐馆

诗涵
养生音乐馆

碧海潮 (古筝)
养生音乐馆

温柔如水 (钢琴)
养生音乐馆

莲语禅心 (竖琴)
养生音乐馆

空梦一场 (古筝)
养生音乐馆

禅心 (竖琴)
养生音乐馆

宝贝之歌 (夜晚的摇篮)
养生音乐馆